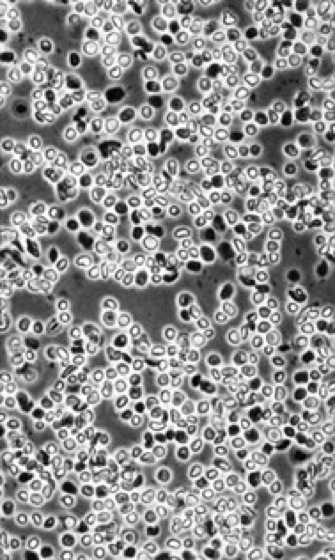

Lexikon der Biologie: Chloroplasten
Chloroplasten [von *chloro –, griech. plastos = geformt], die für die Photosynthese zuständigen, durch Chlorophylle grün gefärbten Plastiden der Algen und Höheren Pflanzen. Für alle Chloroplasten gilt ein im Prinzip gleicher Organisationsplan ( vgl. Infobox ): eine doppelte Hüllmembran begrenzt die Chloroplasten-Matrix (Stroma) zum Cytoplasma hin. Eingebettet in diese Matrix liegt ein internes Membransystem (Thylakoide;vgl. Abb.), der Sitz der photosynthetischen Lichtreaktionen (Thylakoidmembran). Auch bei den Rotalgen, bei deren Plastiden – bedingt durch die akzessorischen Pigmente (Antennenpigmente) Phycocyanin und Phycoerythrin (Phycobiliproteine) – der rote Farbton dominiert (Rhodoplasten), und bei den Braunalgen, die durch das Überwiegen des Carotinoids (Carotinoide) Fucoxanthin bräunlich gefärbt sind (Phaeoplasten), ist der typische Chloroplasten-Funktionstyp realisiert. Vor allem in jungen Sproß- und Blattzellen entwickeln sich während der Ontogenese der meisten Höheren Pflanzen die Chloroplasten aus den kleinen (Durchmesser ca. 1 μm), unpigmentierten und formveränderlichen Proplastiden. Als Hemmformen können bei Lichtmangel sog. Etioplasten entstehen, die ultrastrukturell durch den Besitz von Prolamellarkörpern charakterisiert sind und anstelle des Chlorophylls geringe Mengen an Protochlorophyll(id) enthalten. Bei der lichtinduzierten Ergrünung wandeln sich dann die Etioplasten zu typischen Chloroplasten um. Dies geschieht unter Abbau des tubulären Prolamellarkörpers und der Bildung perforierter Doppelmembranen (Primärthylakoide). Läuft die Chloroplastenentwicklung jedoch ohne Unterbrechung im starken Licht ab, wird kein Etioplastenstadium durchlaufen. Viele experimentelle Evidenzen zeigen, daß Phytochrom in vielfältiger Weise regulierend in die Chloroplastengenese eingreift. So werden z. B. Komponenten des photosynthetischen Elektronentransport-Systems (z. B. Ferredoxin und Plastocyanin), Galactolipide, Carotinoide und Enzyme des Calvin-Zyklus unter dem Einfluß von dunkelrotem Licht stark vermehrt. Es entsteht schließlich in der Chloroplasten-Matrix jene komplexe Thylakoidstruktur mit Grana- (Grana) und Stromapartien, die für den ausdifferenzierten, voll funktionstüchtigen Chloroplasten charakteristisch ist ( vgl. Abb. ). Dieser Typ des granahaltigen ("granulären") Chloroplasten findet sich bei allen Höheren Pflanzen unter Einschluß der meisten Farn- (Farne) und Moospflanzen (Moose) und hochentwickelten Algen (Grünalgen). Im Licht-Mikroskop (maximale Auflösung ca. 250 nm) zeigen sich die Chloroplasten als grüngefärbte, meist plankonvexe bis linsenförmige Partikel mit einem maximalen Durchmesser von 5–10 μm. Ihre Anzahl pro Zelle schwankt je nach Art des Gewebes um 50. Auch die Thylakoidstapelung in den Granabereichen (0,5–0,8 μm hoch, 0,4–0,6 μm breit) ist bei höchster lichtmikroskopischer Auflösung als Muster von dunkelgrünen Granula auf hellerem Untergrund gerade noch erkennbar (daher die Bezeichnung granuläre Chloroplasten). Erst mit der Entwicklung des Elektronenmikroskops (maximale Auflösung ca. 0,2 nm) konnte die komplexe Intimstruktur der Chloroplasten sichtbar gemacht werden. Im Gegensatz zum granahaltigen Chloroplastentyp finden sich besonders im Bereich der Algen davon stark abweichende Strukturtypen. Man spricht von homogenen Chloroplasten wegen ihres im Gegensatz zu den granahaltigen Chloroplasten im Lichtmikroskop homogenen Erscheinens. Sie werden von Einzelthylakoiden (Rotalgen), Thylakoidpaaren (Cryptophyceae) oder Thylakoidtripletts (alle übrigen Algen einschließlich Euglena;Euglenophyceae) in voller Länge durchzogen; die Ausbildung von typischen Grana unterbleibt. Häufig sind nur 1 oder 2 große Chloroplasten pro Algenzelle vorhanden. Diese können eine schraubig aufgewundene (Spirogyra;Zygnemataceae), netzförmige (Cladophora;Cladophoraceae) oder becherförmige (Dunaliella;Dunaliellaceae) Gestalt annehmen. Ebenso kommen Stern-, Platten- und Bandformen vor ( Algen II ). Auch in physiologischer Hinsicht unterscheiden sich die homogenen Chloroplasten von den granahaltigen: Ihre Thylakoide enthalten (Ausnahme Euglena) kein Chlorophyll b, das bei Grünalgen und allen Höheren Pflanzen stets vorkommt. Auch hinsichtlich der aus den Photosyntheseprodukten gebildeten Speicherpolysaccharide gibt es Unterschiede: Während die Assimilations-Stärke bei den Höheren Pflanzen stets intraplastidär entsteht, können diese Polysaccharide (echte Stärke bzw. mit der Stärke verwandte Polysaccharide, bei Euglena z. B. Paramylon) bei den Algen auch extraplastidär abgelagert werden. In den Chloroplasten vieler Algen, aber auch bei Moosen und Farnpflanzen, finden sich sog. Pyrenoide ( Algen I , II), die sehr verschiedengestaltig sein können und als mögliche Bildungsorte für Reservepolysaccharide diskutiert werden. – Chloroplasten-Dimorphismus: Bei bestimmten Photosynthesespezialisten, den sog. C4-Pflanzen (Hatch-Slack-Zyklus), beobachtet man einen ausgeprägten Chloroplasten-Dimorphismus. Im Aufbau des assimilatorischen Gewebes bestehen große Unterschiede zu den normalen C3-Pflanzen: Eine innere Leitbündelscheide enthält große, stärkereiche Chloroplasten, denen Granastapel weitgehend fehlen. Darum ordnet sich ein Kranz von Mesophyllzellen an, deren Chloroplasten granahaltig, aber stärkefrei sind. Dieser Dimorphismus ist Ausdruck einer äußerst effektiven Kooperation der beiden Chloroplasten-Typen bei der Photosynthese. – Semiautonomie der Chloroplasten: Wie Mitochondrien besitzen auch Plastiden genetische Kontinuität, sie sind sui generis, können also nur aus ihresgleichen hervorgehen. Voraussetzung dafür ist der Besitz einer eigenen genetischen Information, der Plastiden-DNA (pt-DNA). Auf das Vorhandensein eines solchen Plastoms (im Gegensatz zum Genom des Zellkerns) schlossen bereits 1909 C. Correns und E. Baur, die für bestimmte Merkmale einen nicht mendelnden, sog. maternalen Erbgang (maternale Vererbung) feststellten. Im Gegensatz zur linearen Kern-DNA (Desoxyribonucleinsäuren) ist die pt-DNA sämtlicher Plastidenformen ringförmig und nicht nucleosomal (Nucleosomen) organisiert, weist also typisch prokaryotische Eigenschaften auf. Die Konturlänge dieser doppelsträngigen DNA-Ringe (Doppelstrang) beträgt knapp 50 μm, was ca. 150 000 Basenpaaren entspricht, und liegt im nativen Zustand in der sog. supercoil-Form (supercoil) vor. Pro Chloroplast können mehrere, bis über 50 identische Kopien dieser zirkulären pt-DNA vorliegen. Die Erforschung des Plastoms mit molekularbiologischen Methoden wurde in den letzten Jahren sehr aktiv vorangetrieben. Die DNA-Sequenz der plastidären Genome mehrerer Arten ist inzwischen vollständig aufgeklärt (z. B. beim Lebermoos, bei Tabak, Reis, Mais, Pinus, Arabidopsis und einigen Algen). Daneben ist inzwischen auch das Genom eines Cyanobakteriums (Synechocystis PCC6803) in seiner gesamten Länge bekannt. Es zeigt sich, daß das plastidäre Genom im Verlauf der Evolution im Vergleich zum Genom der Cyanobakterien, den freilebenden Vorläufern der Plastiden, eine etwa 30fache Größenreduktion erfahren hat. Von den in den heutigen Plastiden benötigten Proteinen wird nur noch ein Bruchteil von etwa 10–20% durch das Plastom selbst codiert und innerhalb der Organelle synthetisiert. Die restlichen Proteine sind Kern-codiert und werden nach ihrer Synthese im Cytoplasma in die Plastiden importiert. Die Translation der plastidären mRNAs findet dabei an den Plastiden-Ribosomen statt, die dem prokaryotischen 70S-Typus angehören. Sie wird spezifisch durch die Hemmstoffe Chloramphenicol und Lincomycin unterbunden, während der für 80S-Ribosomen spezifische Hemmstoff Cycloheximid keine Wirkung zeigt. Aufgrund der Codierung durch den Kern kann die Expression vieler plastidenspezifischer Proteine jedoch durch Cycloheximid gehemmt werden, so z. B. die kleine Untereinheit der Ribulose-1,5-diphosphat-Carboxylase, Ferredoxin und Plastocyanin. Gerade das letztgenannte Plastocyanin demonstriert die Komplexität der Chloroplastengenese nachdrücklich: Um an seinen Wirkort an der der Matrixseite abgewandten E-Seite der Thylakoidmembran zu gelangen, muß dieses an 80S-Ribosomen synthetisierte Protein durch 3 unterschiedliche Membranen geschleust werden, durch die äußere und innere Hüllmembran sowie die Thylakoidmembran. – Die Semiautonomie der Chloroplasten stellt die Frage nach ihrer phylogenetischen Herkunft im Verlauf der biologischen Evolution. Die Endosymbiontenhypothese (Evolution der Eucyte) besagt, daß die heutigen Chloroplasten von einfachen, Photosynthese-aktiven, Sauerstoff-produzierenden Prokaryoten abstammen, die den heutigen Cyanobakterien ähnlich waren. Die ursprünglich heterotrophe Wirtszelle wäre durch diese Symbiose zur photoautotrophen (Photoautotrophie) Pflanzenzelle geworden. Diese Hypothese wird durch eine Reihe eindeutig prokaryotischer Charakteristika der Chloroplasten gestützt (z. B. DNA, Ribosomen, Proteinsynthese und vieles andere). Adenosintriphosphatasen, Aminoacyl-tRNA-Synthetasen, Buntblättrigkeit, Chloroplastenbewegungen, Chlororespiration, cytoplasmatische Vererbung, heteroplasmatisch, Hill-Reaktion, Kompartimentierung, Membrantransport, transfer-RNA, Zelle; Chloroplasten , Photosynthese I.
B.L./R.M.
| |
Chloroplasten Isolierte Chloroplasten. Im Labor ist es heute eine Routinemethode, aus geeigneten Objekten (z. B. Spinatblättern) in gepufferten, isotonischen Isolationsmedien Chloroplasten in hoher Reinheit und Intaktheit zu isolieren. Die Abbildung zeigt eine phasenkontrastmikroskopische Aufnahme isolierter Spinat-Chloroplasten. Die hell erscheinenden Chloroplasten verfügen über eine intakte Hüllmembran, während die dunklen "defekt" sind. Solche isolierte Chloroplasten sind in photosynthetisch voll aktivem Zustand, und es lassen sich die biophysikalischen und biochemischen Teilprozesse der Photosynthese ebenso untersuchen wie eine Reihe von anderen Stoffwechselaktivitäten (z. B. Proteinsynthese, Lipidmetabolismus). Da man solche Experimente unbeeinflußt vom restlichen Zellstoffwechsel in vitro (im Reagenzglas) durchführen kann, lassen sich wichtige Einblicke in die Regulation und Kompartimentierung von Stoffwechselwegen gewinnen. |

Wenn Sie inhaltliche Anmerkungen zu diesem Artikel haben, können Sie die Redaktion per E-Mail informieren. Wir lesen Ihre Zuschrift, bitten jedoch um Verständnis, dass wir nicht jede beantworten können.